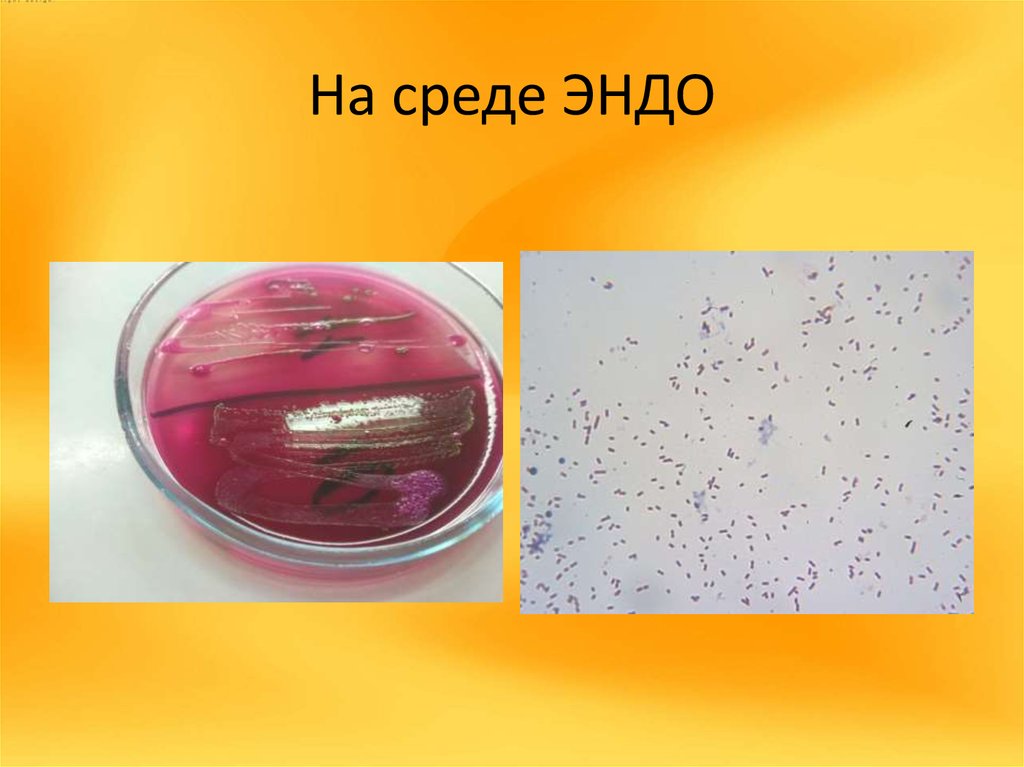

Эндо образование
Steering locked перевод на русский
Материнский капитал сертификат оформление
Fuji sic
То что я тебя обозвал
Кто победил на мистер олимпия 2025
Старые видео саши
Тосно выборы депутатов
Сниму квартиру в краснознаменске без посредников
Спрашивать прятаться
Cherry part
Тайна эдвина друда читать
Фильмография фаннинг
Я отдыхаю на кровати
Эндо образование 109 фотографий